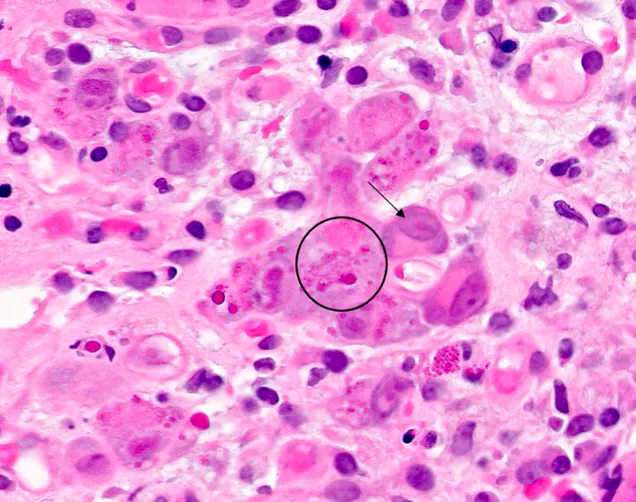
CMV owl's eye inclusion bodies in histology

Herpesviruses - The Latent Menace
- Core Features: All are enveloped, icosahedral, dsDNA viruses that establish lifelong latent infections.
- HSV-1/2: Oral/genital ulcers; devastating temporal lobe encephalitis. Latency in sensory ganglia.
- VZV (HHV-3): Varicella (chickenpox) → Zoster (shingles) reactivation in a dermatome.
- EBV (HHV-4): Infectious mononucleosis; associated with Burkitt lymphoma & nasopharyngeal carcinoma.
- CMV (HHV-5): Retinitis/colitis in immunocompromised; "owl's eye" inclusions.
- HHV-6/7: Roseola infantum (high fever followed by rash).
- HHV-8: Kaposi’s sarcoma.

⭐ CMV is the most common congenital viral infection in the U.S., a major cause of sensorineural hearing loss and neurodevelopmental delay.
Alpha Group (HSV, VZV) - Skin & Nerve Invaders
- Hallmarks: Fast-growing, cytolytic, and establish lifelong latency in sensory nerve ganglia (trigeminal for HSV-1, sacral for HSV-2, dorsal root for VZV).
- HSV-1 & HSV-2:
- Clinical:
- HSV-1: Gingivostomatitis, keratoconjunctivitis, esophagitis.
- HSV-2: Genital & neonatal herpes.
- Diagnosis: PCR is gold standard. Tzanck smear shows multinucleated giant cells.
- Clinical:
- Varicella-Zoster (VZV):
- Primary (Varicella): "Chickenpox" with asynchronous ("dewdrop on a rose petal") vesicular rash.
- Reactivation (Zoster): "Shingles" in a painful, unilateral dermatomal distribution.

⭐ HSV-1 encephalitis is the most common cause of fatal sporadic encephalitis, classically causing hemorrhagic necrosis of the temporal lobes.
Beta Group (CMV, HHV-6/7) - The Slow & Stealthy
- Cytomegalovirus (CMV/HHV-5)
- Transmission: Saliva, urine, blood, sexual, vertical.
- Syndromes:
- Immunocompetent: Mononucleosis-like (heterophile Ab-negative).
- Immunocompromised: Retinitis ("pizza-pie"), pneumonitis, esophagitis (linear ulcers).
- Congenital: Blueberry muffin rash, hepatosplenomegaly, sensorineural deafness.
- Tx: Ganciclovir, valganciclovir.
- HHV-6 / HHV-7
- Disease: Roseola Infantum (Exanthem Subitum).
- Presentation: 3-5 days high fever → fever breaks → rash appears (trunk first).
- Common cause of febrile seizures.
⭐ Histology Classic: CMV is famous for its large cells with prominent basophilic intranuclear "Owl's eye" inclusion bodies.
Gamma Group (EBV, HHV-8) - Oncogenic Opportunists
-
Epstein-Barr Virus (EBV / HHV-4)
- Causes Infectious Mononucleosis (fever, pharyngitis, lymphadenopathy); transmitted via saliva.
- Infects B-cells via CD21 receptor.
- Diagnosis: Monospot test (heterophile antibodies), atypical lymphocytes (Downey cells).
-
Human Herpesvirus 8 (HHV-8)
- Causes Kaposi's Sarcoma, a vascular tumor common in AIDS patients.
- Presents as violaceous lesions on the nose, extremities, and mucous membranes.
- Pathogenesis involves viral-encoded homologues that promote angiogenesis.
⭐ EBV is strongly associated with Burkitt Lymphoma (especially African type, t(8;14) translocation) and nasopharyngeal carcinoma.

Diagnosis & Antivirals - Lab & Pharmacy
- Lab Diagnosis
- PCR: Gold standard for HSV, VZV, CMV detection.
- Tzanck Smear: Multinucleated giant cells (HSV/VZV).
- Biopsy: "Owl's eye" inclusions (CMV), atypical lymphocytes (EBV).
- Antiviral Therapy
- Acyclovir/Valacyclovir for HSV/VZV.
- Ganciclovir/Valganciclovir for CMV.
- Foscarnet for ganciclovir-resistant CMV.
⭐ Foscarnet directly inhibits DNA polymerase without needing viral kinase activation, making it effective against resistant HSV/CMV strains.
- HSV is the most common cause of sporadic temporal lobe encephalitis.
- VZV reactivation causes a painful dermatomal rash (shingles).
- CMV in the immunocompromised shows owl's eye inclusions.
- EBV is linked to infectious mononucleosis, Burkitt lymphoma, and nasopharyngeal carcinoma.
- HHV-6 causes roseola infantum: high fever followed by a rash.
- HHV-8 is the causative agent of Kaposi's sarcoma.
Unlock the full lesson and continue reading
Signup to continue reading this lesson and unlimited access questions, flashcards, AI notes, and more